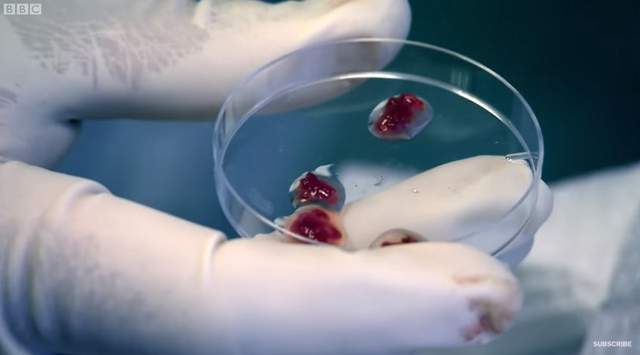
圖片5

閱覽注意《用人肉做漢堡》這份人肉漢堡還要實驗者自己吃下......

圖片來自:youtube.com/channel/UCdsOTr6SmDrxuWE7sJFrkhQ
不知道該說是實驗者變態還是因好奇點開來看的我們怪怪,用人肉做漢堡這實驗太獵奇了,真有人想吃用自己肉做的漢堡嗎?BBC節目《Secrets of Everything》就找來一位英國記者Greg Foot來揭密究竟"人肉的味道"是什麼,但BBC不可能光天化日下切人肉還給你播出來,所以他們改以其他方式製作人肉漢堡,那就是.........
原汁原味的內容在這裡※ 以下有微刺激畫面,請斟酌觀賞
從記者腿中取出肌肉組織出來!
圖片來自:youtube.com/channel/UCdsOTr6SmDrxuWE7sJFrkhQ
(倒)
▼ 光看記者表情就知道這一幕有多痛.........
圖片來自:youtube.com/channel/UCdsOTr6SmDrxuWE7sJFrkhQ
(為什麼要做這個實驗啦OAO)
▼ 把取出的肌肉組織透過顯微鏡觀察發現跟雞肉非常類似

圖片來自:youtube.com/channel/UCdsOTr6SmDrxuWE7sJFrkhQ
圖片來自:youtube.com/channel/UCdsOTr6SmDrxuWE7sJFrkhQ

圖片來自:youtube.com/channel/UCdsOTr6SmDrxuWE7sJFrkhQ
(你這樣以後我要怎麼面對麥香雞漢堡.........)
▼ 不過生的組織是不能直接拿去料理的,所以記者先把肌肉弄熟

圖片來自:youtube.com/channel/UCdsOTr6SmDrxuWE7sJFrkhQ
▼ 弄熟後聞一聞發現味道跟豬肉和羊肉類似

圖片來自:youtube.com/channel/UCdsOTr6SmDrxuWE7sJFrkhQ
(Σ(゚д゚lll))
▼ 接著把組織肉跟其他肉類混合在一起煎成漢堡肉

圖片來自:youtube.com/channel/UCdsOTr6SmDrxuWE7sJFrkhQ
究竟吃起來味道如何?
Greg Foot表示:其實還不錯

圖片來自:youtube.com/channel/UCdsOTr6SmDrxuWE7sJFrkhQ
(´◉㉨◉)
完整影片
※ 再次提醒有刺激性畫面,請斟酌觀賞唷
我到底看了什麼............................(-ι_- )
部分資料來自網路 ( Youtube )

0 則回應
順序: 新│舊























































